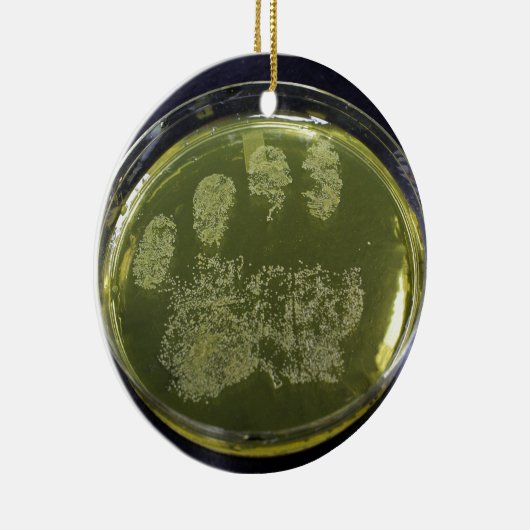
手のペトリ皿の細菌 セラミックオーナメント (右)

オーナメントについて
販売:
このデザインについて
手のペトリ皿の細菌 セラミックオーナメント
マンニットの塩の寒天培地で育つ黄色ブドウ球菌の写真。
自動翻訳
カスタマーレビュー
5つ星評価のうち星5.0全レビュー数 3
レビュー:3
類似商品のレビュー
5つ星評価のうち星5
J.2017年11月27日 • 認証済みのご注文
セラミック製円形オーナメント
Zazzleレビュープログラム
ペパーミントキャンディのオーナメントに、愛犬の写真をコラージュしました。
想像以上に綺麗にプリントされていて驚いています。
大切にします! とても綺麗にプリントされています。
凄いです!!
5つ星評価のうち星5
J.2017年12月4日 • 認証済みのご注文
セラミック製円形オーナメント
Zazzleレビュープログラム
友人へのギフト用に注文しました。
デザインもすごく可愛くて、コラージュした写真も綺麗にプリントされていました。
すごくお勧めです!! 想像よりも綺麗にプリントされていました。
5つ星評価のうち星5
M.2020年12月21日 • 認証済みのご注文
セラミック製円形オーナメント
Zazzleレビュープログラム
イメージどおりに仕上げてくださり、とても気に入りました。ありがとうございました。また記念日の際はぜひお願いします。 色合いも柄もイメージどおりでした。私も妻も満足です。毎年クリスマスに飾ろうと思います。
タグ
その他の情報
商品 ID: 175031149904520247
出品日: 2013/12/24 9:11
レーティング: G
最近閲覧された商品